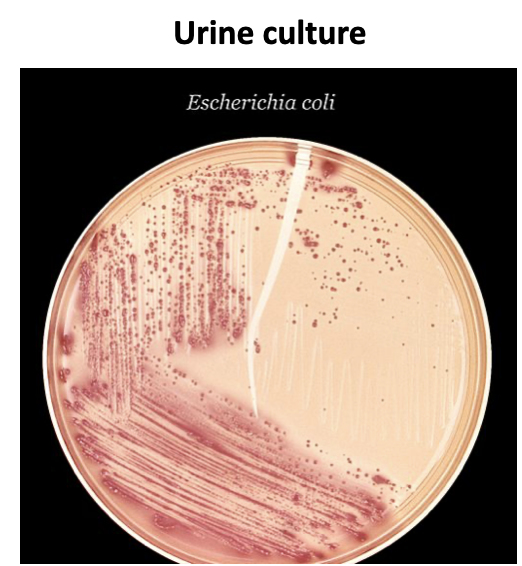

What 5 physiological changes occur in kidney dysfunction?
Filtration failure
Unwell with accumulation of waste substance
Haematuria and proteinuria, low serum protein, including albumin, in blood
Hypertension, water retention (sometimes dehydration because unable to make concentrated urine)
Metabolic acidosis
Anaemia
Vitamin D deficiency and secondary
hyperparathyroidism
What are the 3 types of urinary disorders and give some examples of each
Inflammatory
Infection, including cystitis
Non-infective causes:
1. Metabolic, including diabetic nephropathy
- Immunological
Nephritic syndrome
Nephrotic syndrome
Obstructive
Stones
Benign prostatic hypertrophy
Developmental /Genetic
Polycystic kidneys, horseshoe kidney

What are the names of inflammation of the bladder and kidney?
Bladder:Cystitis
Kidney:Pyelonephritis

What 4 factors do you consider when making a UTI diagnosis?
History
Physical examination
Urine dipstick (link to dipstick practical)
Urine microscopy, culture and sensitivity
What management do you consider for treating a UTI?
Antibiotics:
depending on the severity of illness
the most common bacteria in the local area
modified when the sensitivity from urine culture is
available
Some patients may be very ill and need to be treated as inpatient.
Pain control
Supportive e.g. hydration
Consider imaging if other factors or differential diagnosis.
What 2 ways can the immune system damage the kidneys and how does it present clinically?
Antibody
Inflammatory cells (neutrophils, monocytes/macrophages, T cells)
Presentation:
Nephritic syndrome
Proteinuria
Nephrotic syndrome
Glomerulonephritis def
Inflammation of the nephrons
3 syndromes/symptoms in immunologically caused kidney inflammation
Nephritic syndrome
Proteinuria
Nephrotic syndrome

What are the 5 steps for investigation of immune mediated kidney disease
- History and physical examination
- Urine test
- Blood test: including immunology tests
- Imaging: start with ultrasound
- Kidney biopsy
How does nephritic syndrome present?
Haematuria
Variable amount of proteinuria
May have hypertension, reduced urine output, increased urea and creatinine
What is the epidemiology of IgA nephropathy like?
The most common primary glomerulonephritis world-wide.
Very high prevalence in Far East.
Deposition of IgA antibody in the kidney (detected by immunohistochemistry).
Inflammation and scarring.
About 30% progress to kidney failure.
What are the 2 categories of IgA nephropathy treatment and what is involved in them?
Supportive:
Treat hypertension and reduce proteinuria
First line treatment: angiotensin receptor inhibitor (ARB) (e.g. irbesartan) or angiotensin converting enzyme inhibitor (ACEI) (e.g. ramipril)
Reduce sodium intake
Immunotherapy:
(Many different choices, ongoing clinical trials)
Renal replacement therapy: when reaching late stage kidney disease
Kidney transplantation
Dialysis
Give an organ specific(kidney and lung) disease and how the disease is shared between the organs
Anti-glomerular basement membrane (GBM) antibody mediated: Goodpasture’s disease.
Shared common antigen between lung and kidney: α3chain of type IV collagen
Give 2 conditions immunologically caused inflammatory conds. and their organ-relating factors
Systemic lupus erythematosus (SLE): autoantibodies: antinuclear factor, anti-dsDNA.
Vasculitis: antineutrophil cytoplasm antibody (ANCA).
What are the risk factors and clinical features of diabetic nephropathy
The most common cause of chronic kidney disease and kidney failure in the Western World.
Pathogenesis: inflammation and fibrosis
Hypertension
Poor diabetic control
Smoking
Microalbuminuria
Proteinuria
Association with other complications of diabetes mellitus
Diabetic retinopathy
Diabetic neuropathy
What is the treatment for diabetic nephropathy
Optimised diabetic control
Optimised treatment of hypertension
Reduce proteinuria using ARB or ACEI
Stop smoking
New treatments: SGLT2 inhibitor
Transplantation (including combined pancreas and kidney transplantation
Dialysis
Clinical features of nephrotic syndrome
Peripheral oedema
Severe proteinuria
Low serum albumin
Variable amount of microscopic haematuria
Associated with hyperlipidaemia
Give some causes for nephrotic syndrome
Minimal change glomerulopathy
Membranous nephropathy
Focal segmental glomerulosclerosis
Lupus nephritis
Give the 3 treatment pathways for nephrotic syndrome
Immunotherapy
Traditionally: corticosteroid, cyclophosphamide.
Recent development: tacrolimus, antibody therapy targeting B cell pathway.
Diuretics: to reduce the peripheral oedema.
Prevention of thrombosis: anticoagulation.
What are the key features of minimal-change glomerulopathy?
Most common in children, also affect other age groups
Normal light microscopy
Electron microscopy: podocyte effacement- abnormal flatten appearance (figure below)
Complication: high risk of thrombosis
Where can urinary stones occur?
Kidney
Ureter
bladder
How do urinary stones present?
Pain (abdomen, back-loin).
Blood in urine.
Associated with urine infection.
About 90% of kidney stone are radio-opaque.
What specific treatments can you use for urinary stones?
Shockwave Lithotripsy: High energy ultrasound waves to break up large kidney stones into smaller one.
Ureteroscopy: Through urethra, bladder and ureter.
Percutaneous nephrolithotomy: Small percutaneous incision. Insertion of nephroscope. Stone is removed (may need to broken in smaller pieces).
What are the different types of polycystic kidney disease and what genetic mutation type are they caused by?
Neonatal: autosomal recessive
Adult onset: autosomal dominant
Some patients without family history




